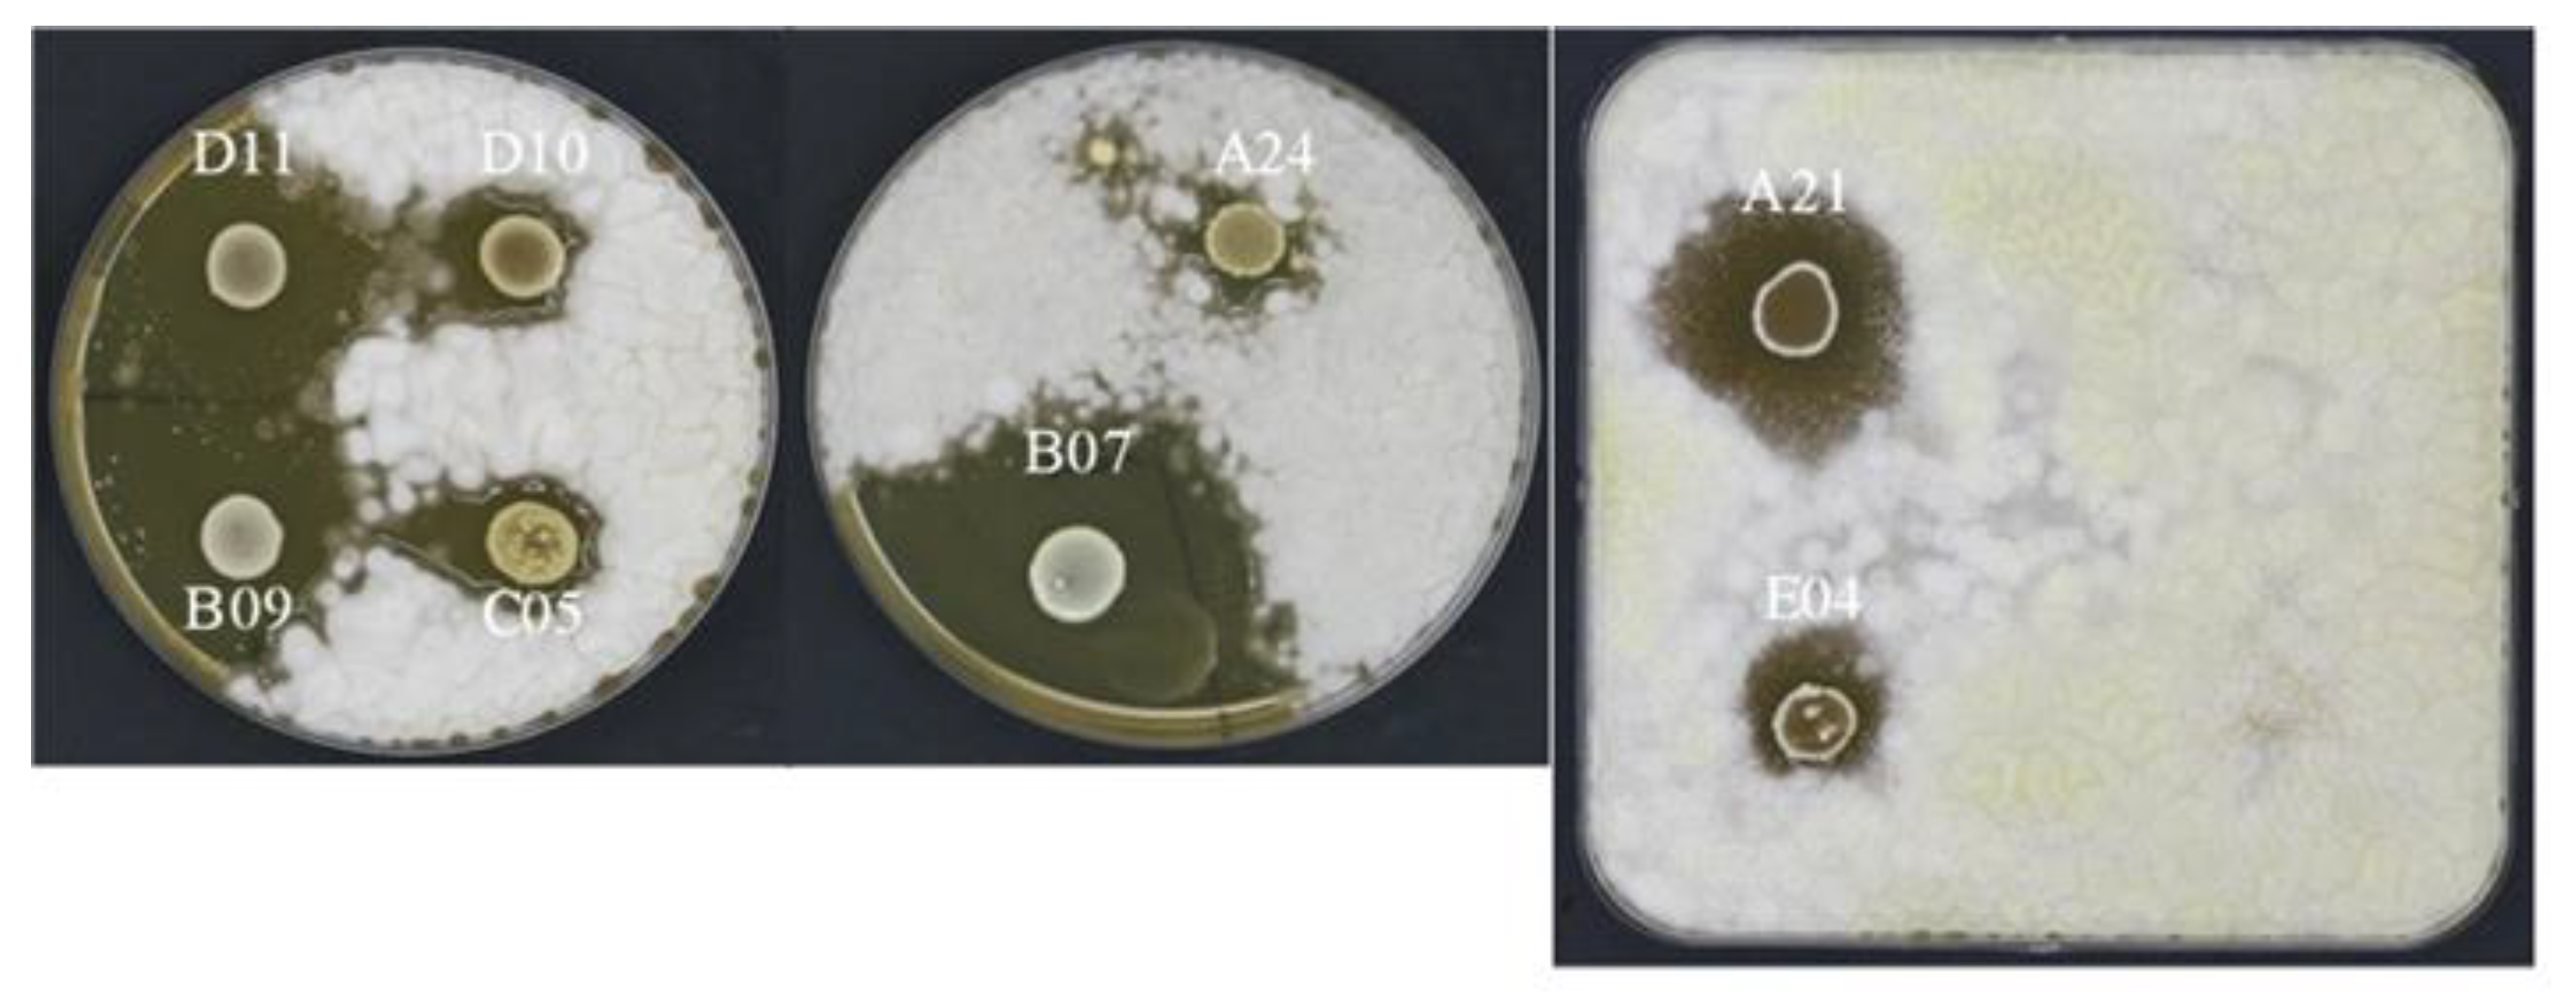
Fermentation 05 00097 g005

Exploration of the Microbial Biodiversity Associated with North Apulian Sourdoughs and the Effect of the Increasing Number of Inoculated Lactic Acid Bacteria Strains on the Biocontrol against Fungal Spoilage
Abstract
1. Introduction
2. Materials and Methods
2.1. Sourdough Sampling, Microbial Analysis, Screening and Isolation of LAB and Yeasts
2.2. Molecular Identification of LAB and Yeast Isolates
2.3. In Vitro Antifungal Activity
2.4. Sourdough Preparation, Bread Making and Antifungal Activity on Bread
3. Results and Discussion
3.1. The Biodiversity of Bacterial and Yeast Isolates from Different Apulian Sourdoughs
3.2. Antifungal Activity of Bacterial Isolates
3.3. Antifungal Activity on Bread Making by Sourdough Preparation Using Microbial Isolates
4. Conclusions
Supplementary Materials
Author Contributions
Funding
Conflicts of Interest
References
- Leroy, F.; De Vuyst, L. Lactic acid bacteria as functional starter cultures for the food fermentation industry. Trends Food Sci. Technol. 2004, 15, 67–78. [Google Scholar] [CrossRef]
- Behera, S.S.; Ray, R.C.; Ray, R.C. Sourdough Bread. Available online: https://www.taylorfrancis.com/ (accessed on 26 September 2019).
- Gobbetti, M.; Gänzle, M. Handbook on Sourdough Biotechnology; Springer Science & Business Media: Berlin/Heidelberg, Germany, 2012; ISBN 978-1-4614-5425-0. [Google Scholar]
- De Vuyst, L.; Vrancken, G.; Ravyts, F.; Rimaux, T.; Weckx, S. Biodiversity, ecological determinants, and metabolic exploitation of sourdough microbiota. Food Microbiol. 2009, 26, 666–675. [Google Scholar] [CrossRef] [PubMed]
- Komlenić, D.K.; Ugarčić-Hardi, Ž.; Jukić, M.; Planinić, M.; Bucić-Kojić, A.; Strelec, I. Wheat dough rheology and bread quality effected by Lactobacillus brevis preferment, dry sourdough and lactic acid addition. Int. J. Food Sci. Technol. 2010, 45, 1417–1425. [Google Scholar] [CrossRef]
- Hammes, W.P.; Brandt, M.J.; Francis, K.L.; Rosenheim, J.; Seitter, M.F.H.; Vogelmann, S.A. Microbial ecology of cereal fermentations. Trends Food Sci. Technol. 2005, 16, 4–11. [Google Scholar] [CrossRef]
- De Vuyst, L.; Van Kerrebroeck, S.; Harth, H.; Huys, G.; Daniel, H.-M.; Weckx, S. Microbial ecology of sourdough fermentations: Diverse or uniform? Food Microbiol. 2014, 37, 11–29. [Google Scholar] [CrossRef]
- Rizzello, C.G.; Calasso, M.; Campanella, D.; De Angelis, M.; Gobbetti, M. Use of sourdough fermentation and mixture of wheat, chickpea, lentil and bean flours for enhancing the nutritional, texture and sensory characteristics of white bread. Int. J. Food Microbiol. 2014, 180, 78–87. [Google Scholar] [CrossRef]
- Gobbetti, M. The sourdough microflora: Interactions of lactic acid bacteria and yeasts. Trends Food Sci. Technol. 1998, 9, 267–274. [Google Scholar] [CrossRef]
- Mariotti, M.; Garofalo, C.; Aquilanti, L.; Osimani, A.; Fongaro, L.; Tavoletti, S.; Hager, A.-S.; Clementi, F. Barley flour exploitation in sourdough bread-making: A technological, nutritional and sensory evaluation. LWT Food Sci. Technol. 2014, 59, 973–980. [Google Scholar] [CrossRef]
- Corsetti, A.; De Angelis, M.; Dellaglio, F.; Paparella, A.; Fox, P.F.; Settanni, L.; Gobbetti, M. Characterization of sourdough lactic acid bacteria based on genotypic and cell-wall protein analyses. J. Appl. Microbiol. 2003, 94, 641–654. [Google Scholar] [CrossRef]
- Torrieri, E.; Pepe, O.; Ventorino, V.; Masi, P.; Cavella, S. Effect of sourdough at different concentrations on quality and shelf life of bread. LWT Food Sci. Technol. 2014, 56, 508–516. [Google Scholar] [CrossRef]
- Capozzi, V.; Russo, P.; Ladero, V.; Fernandez, M.; Fiocco, D.; Alvarez, M.A.; Grieco, F.; Spano, G. Biogenic Amines Degradation by Lactobacillus plantarum: Toward a Potential Application in Wine. Front. Microbiol. 2012, 3, 122. [Google Scholar] [CrossRef] [PubMed]
- Smid, E.J.; Lacroix, C. Microbe-microbe interactions in mixed culture food fermentations. Curr. Opin. Biotechnol. 2013, 24, 148–154. [Google Scholar] [CrossRef]
- Russo, P.; Fares, C.; Longo, A.; Spano, G.; Capozzi, V. Lactobacillus plantarum with Broad Antifungal Activity as a Protective Starter Culture for Bread Production. Foods 2017, 6, 110. [Google Scholar] [CrossRef] [PubMed]
- Palla, M.; Cristani, C.; Giovannetti, M.; Agnolucci, M. Identification and characterization of lactic acid bacteria and yeasts of PDO Tuscan bread sourdough by culture dependent and independent methods. Int. J. Food Microbiol. 2017, 250, 19–26. [Google Scholar] [CrossRef] [PubMed]
- Ghariani, M.; Hamdi, M.; Beneduce, L.; Capozzi, V.; Massa, S. Identification of acetic acid bacteria isolated from Tunisian palm sap. Afr. J. Microbiol. Res. 2017, 11, 596–602. [Google Scholar]
- Wilmotte, A.; Van der Auwera, G.; De Wachter, R. Structure of the 16 S ribosomal RNA of the thermophilic cyanobacterium Chlorogloeopsis HTF (‘Mastigocladus laminosus HTF’) strain PCC7518, and phylogenetic analysis. FEBS Lett. 1993, 317, 96–100. [Google Scholar] [CrossRef]
- Josepa, S.; Guillamon, J.M.; Cano, J. PCR differentiation of Saccharomyces cerevisiae from Saccharomyces bayanus/Saccharomyces pastorianus using specific primers. FEMS Microbiol. Lett. 2000, 193, 255–259. [Google Scholar] [CrossRef]
- Garofalo, C.; Tristezza, M.; Grieco, F.; Spano, G.; Capozzi, V. From grape berries to wine: Population dynamics of cultivable yeasts associated to “Nero di Troia” autochthonous grape cultivar. World J. Microbiol. Biotechnol. 2016, 32, 59. [Google Scholar] [CrossRef]
- Russo, P.; Arena, M.P.; Fiocco, D.; Capozzi, V.; Drider, D.; Spano, G. Lactobacillus plantarum with broad antifungal activity: A promising approach to increase safety and shelf-life of cereal-based products. Int. J. Food Microbiol. 2017, 247, 48–54. [Google Scholar] [CrossRef]
- Plessas, S.; Fisher, A.; Koureta, K.; Psarianos, C.; Nigam, P.; Koutinas, A.A. Application of Kluyveromyces marxianus, Lactobacillus delbrueckii ssp. bulgaricus and L. helveticus for sourdough bread making. Food Chem. 2008, 106, 985–990. [Google Scholar] [CrossRef]
- Rizzello, C.G.; Cassone, A.; Coda, R.; Gobbetti, M. Antifungal activity of sourdough fermented wheat germ used as an ingredient for bread making. Food Chem. 2011, 127, 952–959. [Google Scholar] [CrossRef] [PubMed]
- Zhang, G.; Tu, J.; Sadiq, F.A.; Zhang, W.; Wang, W. Prevalence, Genetic Diversity, and Technological Functions of the Lactobacillus sanfranciscensis in Sourdough: A Review. Compr. Rev. Food Sci. Food Saf. 2019, 18, 1209–1226. [Google Scholar] [CrossRef]
- Corsetti, A.; Lavermicocca, P.; Morea, M.; Baruzzi, F.; Tosti, N.; Gobbetti, M. Phenotypic and molecular identification and clustering of lactic acid bacteria and yeasts from wheat (species Triticum durum and Triticum aestivum) sourdoughs of Southern Italy. Int. J. Food Microbiol. 2001, 64, 95–104. [Google Scholar] [CrossRef]
- Gullo, M.; Romano, A.D.; Pulvirenti, A.; Giudici, P. Candida humilis—Dominant species in sourdoughs for the production of durum wheat bran flour bread. Int. J. Food Microbiol. 2003, 80, 55–59. [Google Scholar] [CrossRef]
- Succi, M.; Reale, A.; Andrighetto, C.; Lombardi, A.; Sorrentino, E.; Coppola, R. Presence of yeasts in southern Italian sourdoughs from Triticum aestivum flour. FEMS Microbiol. Lett. 2003, 225, 143–148. [Google Scholar] [CrossRef]
- Snyder, A.B.; Worobo, R.W. Fungal Spoilage in Food Processing. J. Food Prot. 2018, 81, 1035–1040. [Google Scholar] [CrossRef]
- Oliveira, P.M.; Mauch, A.; Jacob, F.; Waters, D.M.; Arendt, E.K. Fundamental study on the influence of Fusarium infection on quality and ultrastructure of barley malt. Int. J. Food Microbiol. 2012, 156, 32–43. [Google Scholar] [CrossRef]
- Pawlowska, A.M.; Zannini, E.; Coffey, A.; Arendt, E.K. “Green preservatives”: Combating fungi in the food and feed industry by applying antifungal lactic acid bacteria. Adv. Food Nutr. Res. 2012, 66, 217–238. [Google Scholar]
- Ryan, L.A.M.; Zannini, E.; Dal Bello, F.; Pawlowska, A.; Koehler, P.; Arendt, E.K. Lactobacillus amylovorus DSM 19280 as a novel food-grade antifungal agent for bakery products. Int. J. Food Microbiol. 2011, 146, 276–283. [Google Scholar] [CrossRef]
- Lavermicocca, P.; Valerio, F.; Visconti, A. Antifungal Activity of Phenyllactic Acid against Molds Isolated from Bakery Products. Appl. Environ. Microbiol. 2003, 69, 634–640. [Google Scholar] [CrossRef]
- Gerez, C.L.; Torino, M.I.; Obregozo, M.D.; Font de Valdez, G. A ready-to-use antifungal starter culture improves the shelf life of packaged bread. J. Food Prot. 2010, 73, 758–762. [Google Scholar] [CrossRef] [PubMed]
- Gerez, C.L.; Torres, M.J.; Font de Valdez, G.; Rollán, G. Control of spoilage fungi by lactic acid bacteria. Biol. Control 2013, 64, 231–237. [Google Scholar] [CrossRef]
- Pitt, J.I.; Hocking, A.D. Fungi and Food Spoilage, 3rd ed.; Springer: Berlin/Heidelberg, Germany, 2009; ISBN 978-0-387-92206-5. [Google Scholar]
- Bosmans, G.M.; Lagrain, B.; Fierens, E.; Delcour, J.A. The impact of baking time and bread storage temperature on bread crumb properties. Food Chem. 2013, 141, 3301–3308. [Google Scholar] [CrossRef] [PubMed]
- Axel, C.; Zannini, E.; Arendt, E.K. Mold spoilage of bread and its biopreservation: A review of current strategies for bread shelf life extension. Crit. Rev. Food Sci. Nutr. 2017, 57, 3528–3542. [Google Scholar] [CrossRef] [PubMed]
- Kamzolova, S.V.; Vinokurova, N.G.; Shemshura, O.N.; Bekmakhanova, N.E.; Lunina, J.N.; Samoilenko, V.A.; Morgunov, I.G. The production of succinic acid by yeast Yarrowia lipolytica through a two-step process. Appl. Microbiol. Biotechnol. 2014, 98, 7959–7969. [Google Scholar] [CrossRef] [PubMed]
- Morgunov, I.G.; Kamzolova, S.V.; Dedyukhina, E.G.; Chistyakova, T.I.; Lunina, J.N.; Mironov, A.A.; Stepanova, N.N.; Shemshura, O.N.; Vainshtein, M.B. Application of organic acids for plant protection against phytopathogens. Appl. Microbiol. Biotechnol. 2017, 101, 921–932. [Google Scholar] [CrossRef] [PubMed]
- Capozzi, V.; Makhoul, S.; Aprea, E.; Romano, A.; Cappellin, L.; Sanchez Jimena, A.; Spano, G.; Gasperi, F.; Scampicchio, M.; Biasioli, F. PTR-MS Characterization of VOCs Associated with Commercial Aromatic Bakery Yeasts of Wine and Beer Origin. Molecules 2016, 21, 483. [Google Scholar] [CrossRef]
- Capozzi, V.; Yener, S.; Khomenko, I.; Farneti, B.; Cappellin, L.; Gasperi, F.; Scampicchio, M.; Biasioli, F. PTR-ToF-MS Coupled with an Automated Sampling System and Tailored Data Analysis for Food Studies: Bioprocess Monitoring, Screening and Nose-space Analysis. JoVE J. Vis. Exp. 2017, e54075. [Google Scholar] [CrossRef]
- Capozzi, V.; Menga, V.; Digesù, A.M.; De Vita, P.; van Sinderen, D.; Cattivelli, L.; Fares, C.; Spano, G. Biotechnological Production of Vitamin B2-Enriched Bread and Pasta. J. Agric. Food Chem. 2011, 59, 8013–8020. [Google Scholar] [CrossRef]
- Pérez-Ramos, A.; Mohedano, M.L.; López, P.; Spano, G.; Fiocco, D.; Russo, P.; Capozzi, V. In Situ β-Glucan Fortification of Cereal-Based Matrices by Pediococcus parvulus 2.6: Technological Aspects and Prebiotic Potential. Int. J. Mol. Sci. 2017, 18, 1588. [Google Scholar] [CrossRef]
- Arena, M.P.; Capozzi, V.; Spano, G.; Fiocco, D. The potential of lactic acid bacteria to colonize biotic and abiotic surfaces and the investigation of their interactions and mechanisms. Appl. Microbiol. Biotechnol. 2017, 101, 2641–2657. [Google Scholar] [CrossRef] [PubMed]
- Arena, M.P.; Capozzi, V.; Russo, P.; Drider, D.; Spano, G.; Fiocco, D. Immunobiosis and probiosis: Antimicrobial activity of lactic acid bacteria with a focus on their antiviral and antifungal properties. Appl. Microbiol. Biotechnol. 2018, 102, 9949–9958. [Google Scholar] [CrossRef] [PubMed]
- Cheirsilp, B.; Shoji, H.; Shimizu, H.; Shioya, S. Interactions between Lactobacillus kefiranofaciens and Saccharomyces cerevisiae in mixed culture for kefiran production. J. Biosci. Bioeng. 2003, 96, 279–284. [Google Scholar] [CrossRef]
- Franco, W.; Pérez-Díaz, I.M. Microbial interactions associated with secondary cucumber fermentation. J. Appl. Microbiol. 2013, 114, 161–172. [Google Scholar] [CrossRef]
- Sieuwerts, S.; de Bok, F.A.M.; Hugenholtz, J.; van Hylckama Vlieg, J.E.T. Unraveling microbial interactions in food fermentations: From classical to genomics approaches. Appl. Environ. Microbiol. 2008, 74, 4997–5007. [Google Scholar] [CrossRef]
- Alexandre, H.; Costello, P.J.; Remize, F.; Guzzo, J.; Guilloux-Benatier, M. Saccharomyces cerevisiae-Oenococcus oeni interactions in wine: Current knowledge and perspectives. Int. J. Food Microbiol. 2004, 93, 141–154. [Google Scholar] [CrossRef]
- Sieuwerts, S.; Molenaar, D.; van Hijum, S.A.F.T.; Beerthuyzen, M.; Stevens, M.J.A.; Janssen, P.W.M.; Ingham, C.J.; de Bok, F.A.M.; de Vos, W.M.; van Hylckama Vlieg, J.E.T. Mixed-culture transcriptome analysis reveals the molecular basis of mixed-culture growth in Streptococcus thermophilus and Lactobacillus bulgaricus. Appl. Environ. Microbiol. 2010, 76, 7775–7784. [Google Scholar] [CrossRef]
- Viljoen, B.C. The interaction between yeasts and bacteria in dairy environments. Int. J. Food Microbiol. 2001, 69, 37–44. [Google Scholar] [CrossRef]

| Apulian City | Sourdough Identification Letter |
|---|---|
| Monte Sant’Angelo | A |
| Orsara di Puglia | B |
| Trani 01 | C |
| Trani 02 | D |
| Trani 03 | E |
| Ortanova | F |
| Sourdough Source | Bacterial Isolates Code | Sourdough Source | Bacterial Isolates Code | ||
|---|---|---|---|---|---|
| Monte Sant’Angelo | A01 | A14 | Trani 01 | C01 | C06 |
| A02 | A15 | C02 | C07 | ||
| A03 | A16 | C03 | C08 | ||
| A04 | A17 | C04 | C09 | ||
| A05 | A18 | C05 | |||
| A06 | A19 | ||||
| A07 | A20 | Trani 02 | D01 | D07 | |
| A08 | A21 | D02 | D08 | ||
| A09 | A22 | D03 | D09 | ||
| A10 | A23 | D04 | D10 | ||
| A11 | A24 | D05 | D11 | ||
| A12 | A25 | D06 | D12 | ||
| A13 | |||||
| Orsara di Puglia | B01 | B09 | Trani 03 | E01 | E04 |
| B02 | B10 | E02 | E05 | ||
| B03 | B11 | E03 | E06 | ||
| B04 | B12 | ||||
| B05 | B13 | Ortanova | F01 | F06 | |
| B06 | B14 | F02 | F07 | ||
| B07 | B15 | F03 | F08 | ||
| B08 | B16 | F04 | F09 | ||
| F05 | |||||
| Dual Combination Identification Codex | Dual Combination (LAB Isolate + S. cerevisiae) |
|---|---|
| DC1 | A09 + S. cerevisiae |
| DC2 | A10 + S. cerevisiae |
| DC3 | A21 + S. cerevisiae |
| DC4 | B01 + S. cerevisiae |
| DC5 | C02 + S. cerevisiae |
| DC6 | D08 + S. cerevisiae |
| DC7 | D11 + S. cerevisiae |
| DC8 | E05 + S. cerevisiae |
| DC9 | F07 + S. cerevisiae |
| DC10 | B07 + S. cerevisiae |
| DC11 | S. cerevisiae (control, without LAB isolate) |
| Increased Biodiversity Combination Identification Codex | Increased Biodiversity Combination (LAB Isolates + S. cerevisiae) |
|---|---|
| C1 | S. cerevisiae, C02, A10 |
| C2 | S. cerevisiae, C02, A10, A21 |
| C3 | S. cerevisiae, C02, A10, A21, B01 |
| C4 | S. cerevisiae, C02, A10, A21, B01, F07 |
| C5 | S. cerevisiae, C02, A10, A21, B01, F07, E05 |
| C6 | S. cerevisiae, C02, A10, A21, B01, F07, E05, A09 |
| C7 | S. cerevisiae, C02, A10, A21, B01, F07, E05, A09, D08 |
| C8 | S. cerevisiae, C02, A10, A21, B01, F07, E05, A09, D08, D11 |
| C9 | S. cerevisiae, C02, A10, A21, B01, F07, E05, A09, D08, D11, B07 |
| Isolates | A. Flavus | A. Niger | F. Culmorum | P. Chrysogenum | P. Expansum | P. Roqueforti |
|---|---|---|---|---|---|---|
| A01 | +++ (5.0 ± 0.5) | ++ (1.2 ± 0.4) | +++ (5.1 ± 0.5) | −/+ (0) | −/+ (0) | −/+ (0) |
| A02 | +++ (4.3 ± 0.3) | ++ (2.4 ± 0.8) | +++ (6.2 ± 1.1) | −/+ (0) | +++ (5.3 ± 1.1) | −/+ (0) |
| A03 | −/+ (0) | −/+ (0) | +++ (7.2 ± 0.8) | −/+ (0) | −/+ (0) | −/+ (0) |
| A04 | +++ (5.2 ± 0.9) | +++ (6.0 ± 0.2) | +++ (4.0 ± 1.0) | −/+ (0) | +++ (5.0 ± 1.0) | −/+ (0) |
| A05 | +++ (6.2 ± 0.2) | −/+ (0) | ++ (2.1 ± 0.3) | −/+ (0) | −/+ (0) | −/+ (0) |
| A06 | −/+ (0) | −/+ (0) | +++ (3.2 ± 0.5) | −/+ (0) | −/+ (0) | −/+ (0) |
| A07 | −/+ (0) | −/+ (0) | +++ (3.2 ± 0.5) | −/+ (0) | −/+ (0) | −/+ (0) |
| A08 | −/+ (0) | −/+ (0) | ++ (2.0 ± 0.2) | −/+ (0) | −/+ (0) | −/+ (0) |
| A09 | +++ (3.1 ± 0.4) | +++ (8.1 ± 1.2) | +++ (5.4 ± 1.0) | −/+ (0) | ++ (2.5 ± 0.5) | −/+ (0) |
| A10 | ++ (3.0 ± 1.0) | +++ (7.5 ± 0.4) | +++ (4.4 ± 1.0) | −/+ (0) | +++ (4.5 ± 0.5) | −/+ (0) |
| A11 | +++ (10.2 ± 2.3) | +++ (3.2 ± 0.3) | +++ (3.4 ± 0.5) | −/+ (0) | +++ (4.5 ± 0.5) | −/+ (0) |
| A12 | +++ (7.0 ± 2.0) | +++ (6.5 ± 1.0) | +++ (6.2 ± 0.9) | −/+ (0) | +++ (4.4 ± 0.2) | −/+ (0) |
| A13 | +++ (7.4 ± 0.2) | −/+ (0) | ++ (1.1 ± 0.4) | −/+ (0) | −/+ (0) | −/+ (0) |
| A14 | +++ (8.1 ± 0.2) | −/+ (0) | +++ (3.6 ± 0.8) | −/+ (0) | −/+ (0) | −/+ (0) |
| A15 | +++ (8.6 ± 0.4) | −/+ (0) | +++ (3.8 ± 0.8) | −/+ (0) | −/+ (0) | −/+ (0) |
| A16 | +++ (8.2 ± 0.7) | −/+ (0) | +++ (4.7 ± 1.8) | −/+ (0) | −/+ (0) | −/+ (0) |
| A17 | +++ (9.0 ± 0.5) | −/+ (0) | +++ (6.0 ± 0.5) | −/+ (0) | −/+ (0) | −/+ (0) |
| A18 | +++ (5.5 ± 0.5) | −/+ (0) | −/+ (0) | −/+ (0) | −/+ (0) | −/+ (0) |
| A19 | +++ (6.5 ± 0.5) | −/+ (0) | +++ (4.4 ± 0.5) | −/+ (0) | −/+ (0) | −/+ (0) |
| A20 | +++ (9.0 ± 0.5) | −/+ (0) | +++ (4.4 ± 0.5) | −/+ (0) | −/+ (0) | −/+ (0) |
| A21 | +++ (10.0 ± 1.0) | +++ (5.5 ± 0.6) | ++ (2.0 ± 0.3) | −/+ (0) | −/+ (0) | −/+ (0) |
| A22 | +++ (10.6 ± 2.0) | +++ (5.5 ± 1.0) | +++ (5.5 ± 1.0) | −/+ (0) | −/+ (0) | −/+ (0) |
| A23 | +++ (5.2 ± 0.2) | +++ (5.5 ± 0.5) | +++ (4.2 ± 0.2) | −/+ (0) | −/+ (0) | −/+ (0) |
| A24 | ++ (2.0 ± 0.5) | ++ (1.0 ± 0.2) | ++ (2.2 ± 0.4) | −/+ (0) | −/+ (0) | −/+ (0) |
| A25 | +++ (5.0 ± 0.5) | ++ (1 ± 0.5) | +++ (6.0 ± 0.5) | −/+ (0) | −/+ (0) | −/+ (0) |
| B01 | −/+ (0) | −/+ (0) | ++ (2.0 ± 0.5) | −/+ (0) | −/+ (0) | −/+ (0) |
| B02 | +++ (5.5 ± 0.5) | −/+ (0) | +++ (8.0 ± 0.4) | −/+ (0) | −/+ (0) | −/+ (0) |
| B03 | +++ (5.5 ± 0.5) | −/+ (0) | ++ (3.0 ± 0.5) | −/+ (0) | −/+ (0) | −/+ (0) |
| B04 | ++ (2.0 ± 0.5) | −/+ (0) | −/+ (0) | −/+ (0) | ++ (2.0 ± 0.4) | −/+ (0) |
| B05 | ++ (2.0 ± 0.5) | +++ (7.3 ± 0.5) | ++ (1.0 ± 0.2) | −/+ (0) | −/+ (0) | −/+ (0) |
| B06 | +++ (4.0 ± 0.5) | −/+ (0) | ++ (3.0 ± 0.5) | −/+ (0) | −/+ (0) | −/+ (0) |
| B07 | +++ (11.3 ± 2.0) | +++ (3.3 ± 0.3) | +++ (3.5 ± 0.4) | −/+ (0) | −/+ (0) | −/+ (0) |
| B08 | +++ (5.4 ± 0.6) | −/+ (0) | +++ (4.5 ± 0.6) | −/+ (0) | −/+ (0) | −/+ (0) |
| B09 | +++ (10.5 ± 1.0) | ++ (2.0 ± 0.5) | ++ (2.0 ± 0.5) | −/+ (0) | −/+ (0) | −/+ (0) |
| B10 | −/+ (0) | −/+ (0) | ++ (1.0 ± 0.3) | −/+ (0) | −/+ (0) | −/+ (0) |
| B11 | −/+ (0) | −/+ (0) | ++ (2.6 ± 0.2) | −/+ (0) | −/+ (0) | −/+ (0) |
| B12 | −/+ (0) | −/+ (0) | +++ (3.3 ± 0.2) | −/+ (0) | −/+ (0) | −/+ (0) |
| B13 | −/+ (0) | −/+ (0) | +++ (4.0 ± 0.3) | −/+ (0) | −/+ (0) | −/+ (0) |
| B14 | −/+ (0) | −/+ (0) | +++ (4.5 ± 0.5) | −/+ (0) | −/+ (0) | −/+ (0) |
| B15 | −/+ (0) | −/+ (0) | ++ (2.0 ± 0.1) | −/+ (0) | −/+ (0) | −/+ (0) |
| B16 | −/+ (0) | −/+ (0) | −/+ (0) | −/+ (0) | −/+ (0) | −/+ (0) |
| C01 | +++ (6.0 ± 0.5) | ++ (2.0 ± 0.4) | ++ (1.0 ± 0.1) | −/+ (0) | −/+ (0) | −/+ (0) |
| C02 | −/+ (0) | +++ (9.0 ± 1.0) | −/+ (0) | −/+ (0) | −/+ (0) | −/+ (0) |
| C03 | −/+ (0) | −/+ (0) | −/+ (0) | −/+ (0) | +++ (4.6 ± 0.4) | −/+ (0) |
| C04 | −/+ (0) | +++ (4.9 ± 0.5) | −/+ (0) | −/+ (0) | −/+ (0) | −/+ (0) |
| C05 | ++ (2.0 ± 0.4) | ++ (1.0 ± 0.2) | +++ (4.7 ± 0.8) | −/+ (0) | −/+ (0) | −/+ (0) |
| C06 | −/+ (0) | −/+ (0) | −/+ (0) | −/+ (0) | −/+ (0) | −/+ (0) |
| C07 | +++ (5.0 ± 0.4) | −/+ (0) | +++ (6.0 ± 0.2) | −/+ (0) | −/+ (0) | −/+ (0) |
| C08 | +++ (5.0 ± 0.5) | −/+ (0) | −/+ (0) | −/+ (0) | −/+ (0) | −/+ (0) |
| C09 | −/+ (0) | −/+ (0) | +++ (4.0 ± 0.5) | −/+ (0) | −/+ (0) | −/+ (0) |
| D01 | +++ (4.0 ± 0.8) | +++ (7.0 ± 1.1) | +++ (5.0 ± 0.7) | −/+ (0) | −/+ (0) | −/+ (0) |
| D02 | +++ (5.0 ± 0.5) | ++ (1.0 ± 0.3) | +++ (5.0 ± 0.2) | −/+ (0) | −/+ (0) | −/+ (0) |
| D03 | +++ (6.0 ± 0.3) | +++ (9.2 ± 0.4) | +++ (7.0 ± 0.1) | −/+ (0) | −/+ (0) | −/+ (0) |
| D04 | −/+ (0) | −/+ (0) | −/+ (0) | −/+ (0) | −/+ (0) | −/+ (0) |
| D05 | −/+ (0) | ++ (1.0 ± 0.5) | ++ (3.0 ± 0.2) | −/+ (0) | −/+ (0) | −/+ (0) |
| D06 | −/+ (0) | −/+ (0) | +++ (5.0 ± 0.2) | −/+ (0) | −/+ (0) | −/+ (0) |
| D07 | −/+ (0) | ++ (1.0 ± 0.1) | +++ (4.0 ± 0.1) | −/+ (0) | −/+ (0) | −/+ (0) |
| D08 | ++ (3.0 ± 0.3) | +++ (9.0 ± 0.5) | +++ (5.0 ± 0.8) | −/+ (0) | −/+ (0) | −/+ (0) |
| D09 | +++ (6.0 ± 0.2) | +++ (8.0 ± 0.5) | +++ (4.0 ± 0.2) | −/+ (0) | −/+ (0) | −/+ (0) |
| D10 | ++ (1.0 ± 0.1) | +++ (4.0 ± 0.2) | +++ (8.0 ± 0.2) | −/+ (0) | −/+ (0) | −/+ (0) |
| D11 | +++ (10.1 ± 0.4) | +++ (6.0 ± 0.4) | +++ (5.0 ± 0.5) | −/+ (0) | −/+ (0) | −/+ (0) |
| D12 | −/+ (0) | ++ (2.0 ± 0.2) | +++ (5.0 ± 0.4) | −/+ (0) | −/+ (0) | −/+ (0) |
| E01 | −/+ (0) | −/+ (0) | +++ (5.0 ± 0.2) | −/+ (0) | −/+ (0) | −/+ (0) |
| E02 | +++ (4.0 ± 0.4) | −/+ (0) | +++ (6.0 ± 1.0) | −/+ (0) | −/+ (0) | −/+ (0) |
| E03 | ++ (2.0 ± 0.3) | −/+ (0) | +++ (6.0 ± 0.3) | −/+ (0) | −/+ (0) | −/+ (0) |
| E04 | ++ (3.0 ± 1.0) | −/+ (0) | +++ (8.0 ± 2.0) | −/+ (0) | −/+ (0) | −/+ (0) |
| E05 | +++ (6.0 ± 0.3) | +++ (11.0 ± 0.3) | +++ (4.0 ± 0.5) | −/+ (0) | −/+ (0) | −/+ (0) |
| E06 | +++ (6.0 ± 0.5) | ++ (3.0 ± 0.5) | +++ (5.5 ± 0.2) | −/+ (0) | −/+ (0) | −/+ (0) |
| F01 | −/+ (0) | −/+ (0) | ++ (3.0 ± 0.5) | −/+ (0) | −/+ (0) | −/+ (0) |
| F02 | −/+ (0) | −/+ (0) | +++ (13.3 ± 1.1) | −/+ (0) | −/+ (0) | −/+ (0) |
| F03 | +++ (6.6 ± 0.5) | −/+ (0) | ++ (2.0 ± 0.2) | −/+ (0) | −/+ (0) | −/+ (0) |
| F04 | ++ (2.0 ± 0.3) | −/+ (0) | ++ (1.1 ± 0.2) | −/+ (0) | −/+ (0) | −/+ (0) |
| F05 | +++ (5.5 ± 0.5) | +++ (4.1 ± 0.1) | +++ (5.2 ± 0.2) | −/+ (0) | −/+ (0) | −/+ (0) |
| F06 | +++ (5.5 ± 0.2) | +++ (6.0 ± 1.0) | +++ (8.1 ± 0.1) | −/+ (0) | −/+ (0) | −/+ (0) |
| F07 | +++ (5.0 ± 0.2) | +++ (7.1 ± 0.3) | ++ (3.0 ± 0.2) | −/+ (0) | −/+ (0) | −/+ (0) |
| F08 | +++ (5.5 ± 0.4) | +++ (5.5 ± 0.3) | ++ (2.0 ± 0.4) | −/+ (0) | −/+ (0) | −/+ (0) |
| F09 | +++ (5.0 ± 0.4) | ++ (1.0 ± 0.3) | +++ (5.5 ± 0.2) | −/+ (0) | −/+ (0) | −/+ (0) |
© 2019 by the authors. Licensee MDPI, Basel, Switzerland. This article is an open access article distributed under the terms and conditions of the Creative Commons Attribution (CC BY) license (http://creativecommons.org/licenses/by/4.0/).
Share and Cite
Arena, M.P.; Russo, P.; Spano, G.; Capozzi, V. Exploration of the Microbial Biodiversity Associated with North Apulian Sourdoughs and the Effect of the Increasing Number of Inoculated Lactic Acid Bacteria Strains on the Biocontrol against Fungal Spoilage. Fermentation 2019, 5, 97. https://doi.org/10.3390/fermentation5040097
Arena MP, Russo P, Spano G, Capozzi V. Exploration of the Microbial Biodiversity Associated with North Apulian Sourdoughs and the Effect of the Increasing Number of Inoculated Lactic Acid Bacteria Strains on the Biocontrol against Fungal Spoilage. Fermentation. 2019; 5(4):97. https://doi.org/10.3390/fermentation5040097
Chicago/Turabian StyleArena, Mattia Pia, Pasquale Russo, Giuseppe Spano, and Vittorio Capozzi. 2019. "Exploration of the Microbial Biodiversity Associated with North Apulian Sourdoughs and the Effect of the Increasing Number of Inoculated Lactic Acid Bacteria Strains on the Biocontrol against Fungal Spoilage" Fermentation 5, no. 4: 97. https://doi.org/10.3390/fermentation5040097
APA StyleArena, M. P., Russo, P., Spano, G., & Capozzi, V. (2019). Exploration of the Microbial Biodiversity Associated with North Apulian Sourdoughs and the Effect of the Increasing Number of Inoculated Lactic Acid Bacteria Strains on the Biocontrol against Fungal Spoilage. Fermentation, 5(4), 97. https://doi.org/10.3390/fermentation5040097

